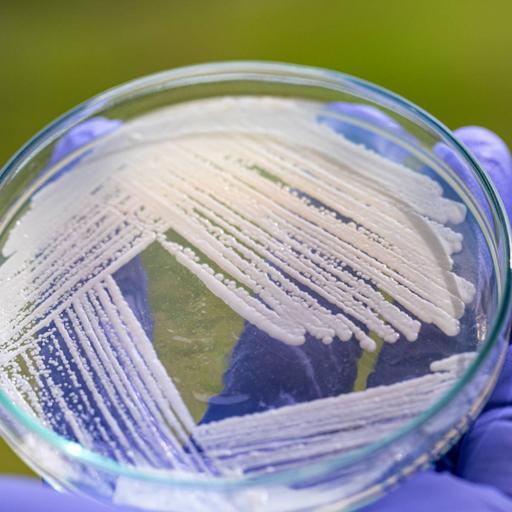

She is a highly enthusiastic and passionate learner of science. A critical thinker who is ready to think out of the box and provide innovative solutions, is also flexible in any work atmosphere. She enjoys writing and reading during her free time.
View more